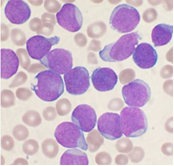

- Razumeti EMS
- Nivo 1
- Nivo 2
- 1. Živeti z EMS
- 2. Statična magnetna polja
- 3. Viri nizkofrekvenčnih EMS
- 4. Viri visokofrekvenčnih EMS
- 5. Učinki EMS
- 6. EMS in zdravje
- 7. Mejne vrednosti za EMS
- 8. Povzetek o EMS
- Nivo 3
- Sevalne obremenitve naprav in sistemov
- SAR center
- e-učenje
- e-dozimeter
- e-izračun
- e-karta EMS
- Pogosta vprašanja
- Pojmovnik
6.1 Ali so študije na uporabnikih mobilnih telefonov pokazale na povečano tveganje za pojav raka?
 V letih 2007 in 2008 se je večina študij, ki so obravnavale povezavo med izpostavljenostjo visokofrekvenčnih EMS mobilnih telefonov in tumorjem na možganih oz. drugimi vrstami tumorjev v predelu glave, osredotočila na majhen predel glave v okolici mobilnega telefona. Preiskovali so predvsem benigno tvorbo na notranjem ušesu, imenovano tudi akustični nevrinom, ter tumorje na obušesni žlezi. Le nekaj študij je preiskovalo zvezo med izpostavljenostjo visokofrekvenčnih EMS radiodifuznih oddajnikov in razvojem tumorjev.
V letih 2007 in 2008 se je večina študij, ki so obravnavale povezavo med izpostavljenostjo visokofrekvenčnih EMS mobilnih telefonov in tumorjem na možganih oz. drugimi vrstami tumorjev v predelu glave, osredotočila na majhen predel glave v okolici mobilnega telefona. Preiskovali so predvsem benigno tvorbo na notranjem ušesu, imenovano tudi akustični nevrinom, ter tumorje na obušesni žlezi. Le nekaj študij je preiskovalo zvezo med izpostavljenostjo visokofrekvenčnih EMS radiodifuznih oddajnikov in razvojem tumorjev.
Pri študijah na živalih, kjer so izpostavljali celotno telo, so preučevali tudi druge oblike raka. In vitro študije so bile usmerjene v iskanje morebitnih bioloških učinkov, ki bi vplivali na razvoj raka pri jakostih EMS, značilnih za mobilno telefonijo.
Študije niso odkrile povečanega tveganja za nastanek tumorja na možganih pri osebah, ki so mobilni telefon uporabljale manj kot deset let. Uporabnikov, ki bi mobilni telefon uporabljali dlje kot deset let, ni bilo veliko, zato je s to skupino povezana večja negotovost. Čeprav nobena od kakovostno opravljenih študij ni pokazala pomembno povečanega tveganja, pa so pustile odprto možnost majhnega do zmernega povečanja tveganja pojava glioma in akustičnega nevrinoma pri osebah, ki so pogosti uporabniki mobilnega telefona.
6.2. Kaj kažejo izsledki študije INTERPHONE ?
 Mednarodna raziskava Interphone je analizirala povezavo med štirimi tipi tumorjev, ki se nahajajo v tkivih, ki so med pogovorom z mobilnim telefonom najbolj izpostavljeni in se v njih absorbira največ energije (gliom, meningiom, akustični nevrinom, tumor obušesnih žlez) in uporabo mobilnega telefona. Pričela se je že v letu 2000, vanjo je bilo vključenih 13 držav in 21 institucij, stala je 19 milijonov evrov ter skupno obravnavala skoraj 3000 primerov gliomov in 2500 primerov meningiomov, več kot 1000 primerov akustičnega nevroma, 100 primerov tumorjev obušesnih žlez ter več kot 7000 posameznikov v kontrolni skupini. Vse raziskovalne institucije so uporabljale enako metodologijo raziskav, ki so potekale kot študije primerov in kontrol v obliki intervjujev. Bistveni prednosti študije Interphone sta prav enotna metodologija in veliko število obravnavanih primerov, k čemur je veliko pripomoglo koordiniranje študije, ki ga je opravljala Mednarodna agencija za raziskave raka (IARC).
Mednarodna raziskava Interphone je analizirala povezavo med štirimi tipi tumorjev, ki se nahajajo v tkivih, ki so med pogovorom z mobilnim telefonom najbolj izpostavljeni in se v njih absorbira največ energije (gliom, meningiom, akustični nevrinom, tumor obušesnih žlez) in uporabo mobilnega telefona. Pričela se je že v letu 2000, vanjo je bilo vključenih 13 držav in 21 institucij, stala je 19 milijonov evrov ter skupno obravnavala skoraj 3000 primerov gliomov in 2500 primerov meningiomov, več kot 1000 primerov akustičnega nevroma, 100 primerov tumorjev obušesnih žlez ter več kot 7000 posameznikov v kontrolni skupini. Vse raziskovalne institucije so uporabljale enako metodologijo raziskav, ki so potekale kot študije primerov in kontrol v obliki intervjujev. Bistveni prednosti študije Interphone sta prav enotna metodologija in veliko število obravnavanih primerov, k čemur je veliko pripomoglo koordiniranje študije, ki ga je opravljala Mednarodna agencija za raziskave raka (IARC).
Kljub skrbnemu načrtovanju študije rezultati v veliko primerih kažejo na manjše tveganje za nastanek nekaterih oblik tumorjev ob porabi mobilnih telefonov kot v primeru neuporabe. Tako je razmerje obetov (Odds ratio ali OR) za redne uporabnike mobilne telefonije za gliom 0,81 in za meningiom 0,79, kar pomeni, da študija ugotavlja, da je tveganje za nastanek glioma in meningioma med rednimi uporabniki mobilnega telefona manjše kot med neuporabniki. Tudi za dolgotrajne uporabnike (uporabniki več kot 10 let) študija ne nakazuje na povečanje OR: za gliom znaša OR 0,98, za meningiom pa znaša 0,83.
Kritični pregled znanstvenih raziskav o vplivu EMS mobilnih telefonov je pripeljal do zaključka, da je povezava med gliomom in akustičnim nevrinomom ter sevanjem mobilnih telefonov omejena, medtem ko je povezava med vsemi drugimi vrstami raka nezadostna za izoblikovanje končnih zaključkov.
IARC ni kvantitativno ocenila tveganja, kljub temu pa je ugotovila, da določene epidemiološke raziskave med uporabniki mobilnih telefonov kažejo na 40% povečanje tveganja za nastanek glioma ter 15% povečanje tveganja za meningiom med najbolj pogostimi uporabniki (povprečno vsaj 30 minut na dan v zadnjih 10 letih).
Celovit in kritičen pregled vseh drugih relevantnih raziskav je privedel skupino do sklepa, da je povezava med rakom in poklicno izpostavljenostjo sevanjem kakor tudi izpostavljenostjo sevanjem iz okolja (oddajniki, bazne postaje) nezadostna za izoblikovanje končnih zaključkov.
6.3 Ali so laboratorijske študije na živalih pokazale na povečano tveganje za pojav raka?
Opravljenih je bilo precej študij na laboratorijskih živalih, ki so preučevale morebitne vplive VF sevanja na pojav raka. Večina ni našla nobene povezave. Ena od izjem je bila študija iz leta 1997, ki je miši, dovzetnih za limfom, vsakodnevno 18 mesecev izpostavljala VF EMS, podobnim tistim, ki jih oddajajo mobilni telefoni. Raziskovalci so pri izpostavljenih miših opazili povečano število primerov limfoma.
 Drugi raziskovalci, ki so leta 2002 opravili podoben poskus, pa niso zabeležili pomembnega vpliva na število primerov limfoma pri izpostavljenih miših. Tudi nekatere druge študije so skušale ugotoviti, ali že sama izpostavljenost VF sevanjem lahko sproži nastanek katere koli vrste raka pri normalnih živalih ali pri živalih z genetsko predispozicijo. Nekatere študije so se ukvarjale z vprašanjem, ali lahko izpostavljenost VF sevanjem pospeši razvoj tumorjev, ki so nastali zaradi rakotvornih kemikalij, rentgenskega sevanja ali UV svetlobe. Nobena ni zabeležila pomembnega povečanja števila primerov tumorja, vendar pa so v večini primerov uporabljali razmeroma nizke ravni izpostavljenosti.
Drugi raziskovalci, ki so leta 2002 opravili podoben poskus, pa niso zabeležili pomembnega vpliva na število primerov limfoma pri izpostavljenih miših. Tudi nekatere druge študije so skušale ugotoviti, ali že sama izpostavljenost VF sevanjem lahko sproži nastanek katere koli vrste raka pri normalnih živalih ali pri živalih z genetsko predispozicijo. Nekatere študije so se ukvarjale z vprašanjem, ali lahko izpostavljenost VF sevanjem pospeši razvoj tumorjev, ki so nastali zaradi rakotvornih kemikalij, rentgenskega sevanja ali UV svetlobe. Nobena ni zabeležila pomembnega povečanja števila primerov tumorja, vendar pa so v večini primerov uporabljali razmeroma nizke ravni izpostavljenosti.
V zadnjih letih je bilo na laboratorijskih živalih opravljenih precej študij vseživljenjske ali dolgotrajne izpostavljenosti- Živali so izpostavljali GSM signalom jakosti 900 MHz ter drugim VF signalom višjih jakosti izpostavljenosti kot v predhodnih študijah. Vse študije so pokazale, da ni nikakršnega učinka VF sevanj na tveganje za razvoj tumorjev niti pri višjih izpostavljenostih. Ena od študij je pokazala na krajšo stopnjo preživetja izpostavljenih živali, vendar pa je ta ugotovovitev še vedno nepojasnjena.
6.4 Ali so študije na celičnih kulturah pokazale ne genetske učinke?
 Znanstveniki so preučevali številne možne učinke visokofrekvenčnih elektromagnetnih sevanj na celične kulture (in-vitro). Večina študij, opravljenih pred letom 2007, ni ponudila nikakršnih izsledkov o učinkih VF sevanj na izolirane celice in tkiva pri jakostih, ki so nižje od tistih, ki povzročijo učinek segrevanja.
Znanstveniki so preučevali številne možne učinke visokofrekvenčnih elektromagnetnih sevanj na celične kulture (in-vitro). Večina študij, opravljenih pred letom 2007, ni ponudila nikakršnih izsledkov o učinkih VF sevanj na izolirane celice in tkiva pri jakostih, ki so nižje od tistih, ki povzročijo učinek segrevanja.
V zadnjih letih pa je bilo izvedenih precej in vitro študij, ki so preučevale tako učinek na DNK kot tudi na druge celične komponente in precese.
Ena od študij je pokazala, da je zaradi izpostavljenosti prišlo do večje stopnje poškodb DNK v povezovalnih celicah tkiv (fibroblasti), ne pa v belih krvničkah (limfocitih). Vendar pa je znanstvena veljavnost te študije nejasna, kar otežuje interpretacijo izsledkov.
Neka druga študija je zaznala spremembe v številu določenih kromosomov (manjkajoči ali dodatni kromosomi) v človeških belih krvničkah.
Študije drugih celičnih sestavin so prinesle različne rezultate, povezane s povečano aktivnostjo nekaterih encimov, prisotnostjo prostih radikalov začetkom propadanja celic. Vendar pa so študije med seboj neskladne, pomen opazovanih učinkov za zdravje pa ostaja nejasen.
6.5. Ali lahko EMS ekstremno nizkih frekvenc povečajo tveganje za pojav otroške levkemije in drugih oblik raka?
Leta 2002 je Mednarodna agencija za raziskave raka (IARC) razvrstila magnetna polja ekstremno nizkih frekvenc med “možne kancerogene snovi za ljudi« (skupina 2B). To je temeljilo na epidemioloških študijah, ki so pokazale, da je pri otrocih, ki so izpostavljeni magnetnim poljem višjim od 0,3-0,4 µT (24-urno povprečje), večja verjetnost za razvoj levkemije. Eksperimentalne študije na živalih niso podprle teh ugotovitev.
Leta 2002 je Mednarodna agencija za raziskave raka (IARC) razvrstila magnetna polja ekstremno nizkih frekvenc med “možne kancerogene snovi za ljudi« (skupina 2B). To je temeljilo na epidemioloških študijah, ki so pokazale, da je pri otrocih, ki so izpostavljeni magnetnim poljem višjim od 0,3-0,4 µT (24-urno povprečje), večja verjetnost za razvoj levkemije. Eksperimentalne študije na živalih niso podprle teh ugotovitev.
Poleg tega je Mednarodna agencija za raziskave raka ugotovila, da ni dokazov o povezavi med magnetnimi polji ekstremno nizkih frekvenc in različnimi drugimi vrstami raka.
Električna polja ekstremno nizkih frekvenc je Mednarodna agencija za raziskave raka opredelila kot “ni mogoče klasificirati kot kancerogeno za ljudi”.
Potencialno povezavo med polji ekstremno nizkih frekvenc in otroško levkemijo so obravnavale številne epidemiološke študije, ki pa niso našle dokončnih dokazov, zato so potrebne nadaljnje študije. V zadnjih nekaj letih ni bila objavljena nobena pomembna študija, ki bi obravnavala katerokoli vrsto raka.
Nedavna študija na ljudeh je pokazala povezavo med okvarami v DNK in otroško levkemijo. Vendar pa ima študija preveč pomanjkljivosti, da bi lahko iz nje izvedli sklepe o neposredni povezavi.
Študije na laboratorijskih živalih so pokazale le malo izsledkov, ki bi potrjevali domnevo, da lahko zgolj izpostavljenost magnetnim poljem ekstremno nizkih frekvenc povzroči katerokoli vrsto raka ali vpliva na obstoječe tumorje.
Obstaja nekaj nedoslednih izsledkov o tem, da lahko magnetna polja jakosti okrog 100 µT pospešijo razvoj tumorjev, ki jih povzročijo drugi kancerogeni, vendar pa večina študij, ki so preučevale tovrstne kombinirane učinke, ni našla povezave. Izsledki nedavnih študij so potencialno koristni pri pojasnjevanju mehanizmov in nedoslednosti predhodnih ugotovitev, vendar pa jih dodatni neodvisni poskusi niso potrdili in niso dovolj, da bi Mednarodna agencija za raziskave raka spremenila stališče, da so eksperimentalni dokazi o kancerogenosti magnetnih polj ekstremno nizkih frekvenc nezadostni. To pomeni, da zaradi velikih kvalitativnih in kvantitativnih omejitev na podlagi eksperimentalnih študij ne moremo sklepati niti na prisotnost niti na odsotnost kancerogenih učinkov.
Laboratorijske študije na izoliranih celicah in tkivih (in vitro študije) lahko ponudijo informacijo o mehanizmih poškodb celic. Objavljene in-vitro študije v tem trenutku ne morejo pojasniti epidemioloških opažanj, vendar pa hkrati tudi niso v nasprotju z njimi. Pokazale so veliko učinkov polj ekstremno nizkih frekvenc in očitno je, da izpostavljenost EMS lahko vpliva na številne celične komponente, procese in sisteme. Dejstvo, da eksperimentalne študije epidemioloških izsledkov o otroški levkemiji niti ne potrjujejo niti ne pojasnjujejo znanih mehanizmov, je zanimivo in razrešitev tega protislovja je ena od glavnih raziskovalnih prioritet.
6.6. Ali lahko izpostavljenost EMS ekstremno nizkih frekvenc povzroči glavobole in druge zdravstvene učinke?
Nekateri ljudje pripisujejo glavobole, utrujenost in vrtoglavico EMS. Zaradi tega se je pojavila skrb, da so določene osebe bolj občutljive za EMS kot druge.
 Prevladujoče mnenje znanstvenikov je, da teh simptomov ne moremo pripisati izpostavljenosti EMS, temveč so posledica “nocebo” učinka; to je učinek, ki ga povzroča pričakovanje ali prepričanje o tem, da je nekaj škodljivo.
Prevladujoče mnenje znanstvenikov je, da teh simptomov ne moremo pripisati izpostavljenosti EMS, temveč so posledica “nocebo” učinka; to je učinek, ki ga povzroča pričakovanje ali prepričanje o tem, da je nekaj škodljivo.
Ker mobilne telefone uporabljamo v neposredni bližini glave, obstaja skrb, da bi lahko škodljivo vplivali na možgane.
Obstajajo rezultati raziskav, ki kažejo, da izpostavljenost VF EMS lahko vpliva na delovanje možganov in spanje. Vendar pa je s tem povezani vpliv na zdravje neznan in tudi mehanizem delovanja še ni pojasnjen. Potrebne so nadaljnje raziskave teh učinkov.
Številne študije razvoja in razmnoževanja živali so pokazale, da VF EMS pri nivojih, ki močno presegajo mejne vrednosti, lahko povzročijo prirojene anomalije. To velja za primere, ko je izpostavljenost dovolj visoka, da pride do precejšnjega segrevanja tkiva. Pri nižjih nivojih izpostavljenosti tega niso zaznali. Novejše študije so preučevale morebitni vpliv na razvoj živali pred rojstvom ter na plodnost moških, ki delajo v bližini močnih virov VF EMS. Vendar pa iz teh študij zaradi metodoloških omejitev ni mogoče potegniti dokončnih sklepov.
Le nekaj študij je preučevalo morebitne vplive mobilnih telefonov na otroke, čeprav se nekateri bojijo, da so otroci zaradi razvijajočega se živčnega sistema bolj občutljivi od odraslih. Njihovi možgani so bolj prevodni, njihove glave pa lahko absorbirajo več energije, ki jo oddajajo mobilni telefoni. Poleg tega bo pri osebah, ki so že kot otroci začele uporabljati mobilni telefon, skupna življenjska izpostavljenost višja kot pri tistih, ki so mobilni telefon začele uporabljati v odrasli dobi.
Izpostavljenosti EMS ekstremno nizkih frekvenc nekateri pripisujejo številne simptome: rdečico, občutek ščemenja in pekoč občutek, utrujenost, glavobol, težave pri koncentraciji, slabost in neenakomerno bitje srca. Pojem “elektromagnetna hipersenzitivnost” se je razvil na podlagi poročil oseb, ki so opisane simptome pripisovale električnim in/ali magnetnim poljem oziroma bližini delujoče električne opreme. Znanstvene študije niso pokazale povezave med izpostavljenostjo poljem ekstremno nizkih frekvenc in opisanimi simptomi.
